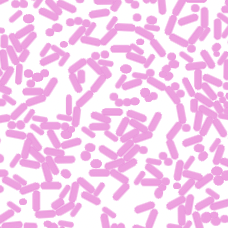
Fusobacterium infection facilitates the development of endometriosis through the phenotypic transition of endometrial fibroblasts

The genetic basis of endometriosis and comorbidity with other pain and inflammatory conditions
- kim6691
- May 9, 2024
- 1 min read
Updated: May 9, 2024
Type: Article Published: March 13, 2023
Journal: Nature Genetics
Image: Rahmioglu, N., Mortlock, S., Ghiasi, M. et al.
Key Takeaways: A genome-wide association study of 60,674 cases and 701,926 controls identified 42 genome-wide significant loci for overall endometriosis, 31 of which had not been previously reported.
A significant finding was the link of many of the genes, such as SRP14/BMF, GDAP1, MLLT10, BSN and NGF, plus ‘hormone regulator’ genes SYNE1/ESR1 and FSHB, to mechanisms of pain perception and maintenance.
The genetic correlation analysis highlighted significant correlations between endometriosis and 11 pain conditions—including migraine, headache, and chronic back pain. There were also genetic correlations between endometriosis and the inflammatory conditions asthma and osteoarthritis. The identification of genes with strong evidence for causal association with endometriosis should inform new targeted research with the potential to identify new or established treatment targets for endometriosis.

Comments